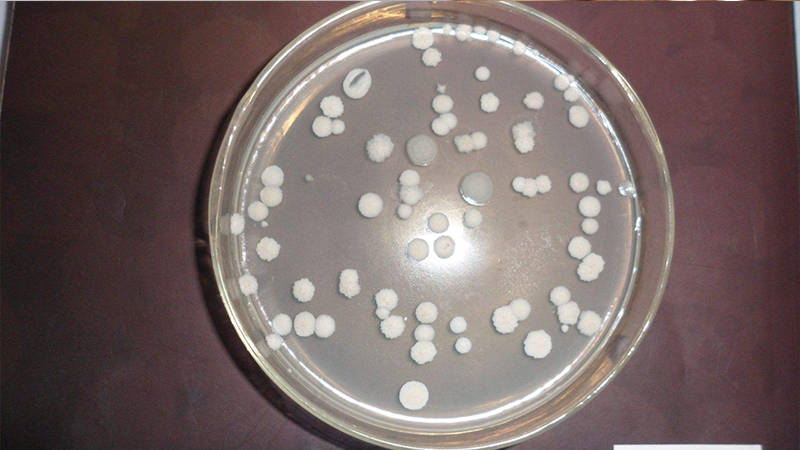

培养基种类及应用场景 培养基的种类及应用
培养基种类及应用场景 培养基的种类及应用
化学分类:①天然培养基指用化学成分不明确的天然物质做成的培养基,如鸡的肝脏研磨液、人的血浆。②组合培养基又称为合成培养基或综合培养基,是一类按微生物的营养要求精确设计后用多种高纯化学试剂配制成的培养基。如葡萄糖铵盐培养基、淀粉硝酸盐培养基等。③半组合培养基指一类主要以化学试剂配制,同时还加有某种或某些天然成分的培养基。例如,马铃薯蔗糖培养基。物理分类:①液体培养基80%~90%是水,其中配有可溶性的或不溶性的营养成分的培养基。②固体培养基一类配制成的固体状态的基质。根据性质又分为固化培养基、非可逆性固化培养基、天然固态培养基、滤膜。③半固体培养基指在液体培养基中加入少量的凝固剂而配制成的半固体状态的培养基。④脱水培养基又称预制干燥培养基,指含有除水分外的一切成分的商品培养基。微生物分类:①选择性培养基:一类根据某微生物的特殊营养要求或其对某化学、物理因素的抗性而设计的培养基,具有使混合菌样中的劣势菌变成优势菌的功能,广泛用于菌种筛选等领域。②鉴别培养基:一类在成分中加有能与目的菌的无色代谢产物发生显色反应的指示剂,从而达到只须用肉眼辨别颜色就能方便的从近似菌落中找出目的菌菌落的培养基。例如,伊红美蓝乳糖培养基(EMB)。
-
- 你的三大未解之谜是什么呀 十大未解之谜是什么?
-
2024-01-29 14:19:48
-
- 短尾信天翁数量 白头翁鸟是国家保护动物吗
-
2024-01-29 14:17:43
-
- 端午节为什么要吃三黄 端午节吃红色的食物
-
2024-01-29 14:15:37
-
- 端午节的由来的英语作文 关于端午节的风俗作文英语
-
2024-01-29 14:13:31
-
- 电脑上打字不显示汉字怎么办win10(win10电脑不能打汉字怎么恢复正常)
-
2024-01-29 06:39:14
-
- 08ms小队(机动战士高达 第08MS小队 动漫)
-
2024-01-29 06:37:09
-
- 小米截图快捷手势设置(小米截图快捷手势设置在哪里)
-
2024-01-29 06:35:04
-
- 品胜和罗马仕移动电源哪个好用(品胜的充电宝好还是罗马仕的充电宝好)
-
2024-01-29 06:32:59
-
- 黄海新旗胜 碰撞(黄海旗胜f1新车多少钱)
-
2024-01-29 06:30:54
-
- 红米note8上市时间(天玑6020和高通骁龙680哪个好)
-
2024-01-29 06:28:49
-
- iphone12强制关机方法(iphone12怎么强制关机重启)
-
2024-01-29 06:26:44
-
- 王者荣耀走位失灵断触是屏幕的问题吗(王者荣耀触屏失灵一招解决)
-
2024-01-29 06:24:39
-
- 苹果6手机开不了机怎么解决(iphone6强制开机也开不起)
-
2024-01-29 06:22:34
-
- 米动手表青春版手机连不上(米动手表青春版 链接app重新升级)
-
2024-01-29 06:20:30
-
- 回声地图线上征集①|你未必听过这么丰富的回声
-
2024-01-28 19:53:26
-
- 医生提醒:身体出现这些表现,可能是患上佝偻病的征兆!及时检查
-
2024-01-28 19:51:21
-
- 贵阳花语墅别墅房价 贵阳花语墅沙盘
-
2024-01-28 19:49:16
-
- 缅北电诈团伙 缅北电诈老板是什么人
-
2024-01-28 19:47:11
-
- 6种常用于消化不良、胃胀、慢性胃肠炎的中成药。建议收藏
-
2024-01-28 19:45:06
-
- 3分钟搞懂QC、QA、IQC、IPQC的区别
-
2024-01-28 19:43:01



农村40万存款算穷吗
ins什么意思,女生ins是什么意思?